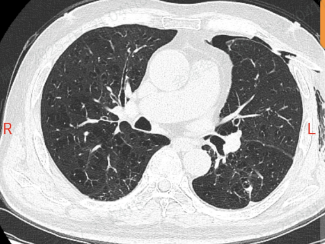

手术室
无影灯
那些
你不知道的事
手术室的门,曾让不少人心里发怵。

有人被反复的病痛折磨得没了力气,有人带着孩子看病时手心冒汗。
但在这里,靠谱的技术和贴心的照顾,让这扇门变成了通往好转的路,让绝望的人看到希望,让紧张的人慢慢放松。
P
art1
从 “漏气的肺” 到顺畅呼吸
老李的求医路
湖南长沙的老李,怎么也想不到一次胸闷会拖成一年的 “煎熬”。
他这肺就像个漏气的气球,气胸反反复复,隔几周就得住院抽气、插管子,CT 片上的肺大疱密密麻麻,医生说这是难治性气胸,传统手术风险不小。

一年里,引流管成了他形影不离的 “负担”,连好好吸口气都成了奢望。
后来,老李在抖音上刷到一条视频,说有种复合修补术能治这种难缠的气胸。
抱着最后一丝希望,他坐火车来了北京积水潭医院郑州医院(郑州市中心医院)。
接诊的余耀华医生仔细看了他的片子,打了个比方:“您这肺 需要用‘ 编织补漏+精准封堵 ’ 的组合拳,就像修补一件破毛衣,光缝几针不顶用,得用‘编织补漏加精准封堵’的法子。”
文字点击切换
手术前,团队用 3D 成像把病灶看得清清楚楚。

进了手术室,高清胸腔镜像 “放大镜” 一样找到漏口,医生精准修补后,又用上可吸收的生物材料 “补丁”,最后注入自体血促进恢复。
每一步都做得特别细致,就像在毫米大小的地方 “绣花”。

术 前
术后24小时
术后第三天,老李就能带着引流瓶在走廊慢慢走了;第七天复查,肺终于好好张开了,那根带了一年的引流管终于拔掉了。
P
art2
从 “紧张攥拳” 到当天出院
孩子的手术经历
早上七点半,5 岁的宝宝被推进手术室时,小手攥得紧紧的,指节都发白了。
他要做腹股沟疝气手术,虽然是微创手术,但孩子心里怕得不行。
麻醉师蹲下来,轻声说:“宝宝别怕,今天用的麻醉方式不一样,你舒舒服服睡一觉,醒来就能见爸爸妈妈,很快就能回家。”
孩子紧张的眼神慢慢放松,手指也松开了。

以前做这类手术,全身麻醉后孩子醒得慢,还容易恶心呕吐,得住院观察好几天,家长又急又花钱。
现在用的 “局部神经阻滞加浅镇静” 法子,就像给目标区域的神经 “冻” 住了,再加上轻轻的镇静,孩子术中不疼也没感觉,还避免了深度麻醉对身体的影响。

孩子醒过来时,第一眼就看到了守在旁边的爸爸妈妈,脑子清清爽爽的,一点不难受。
妈妈喂他喝了水,这爱学习的小家伙,在复苏室里还拿起笔做起了数学题。

回到病房后,他就能吃点易消化的东西,当天下午就办了出院手续。
新的麻醉方案不仅让孩子少受罪,费用也降了近三成。对家长来说,少花钱、少操心,孩子能快点好起来,就是最实在的安慰。
医学的进步,就在这些实实在在的改变里:让塌陷的肺重新鼓起,让紧张的孩子轻松出院,用技术解决难题,用真心温暖人心,这就是医疗最本真的样子。
郑州市中心医院
新媒体矩阵

官方微信

互联网医院

官方抖音

官方视频号

官方小红书号

官方微博

官方头条号

北京积水潭医院郑州医院
官方微信

官方快手号


精彩推荐
喜欢就奖励一个
和“在看”呗![]()